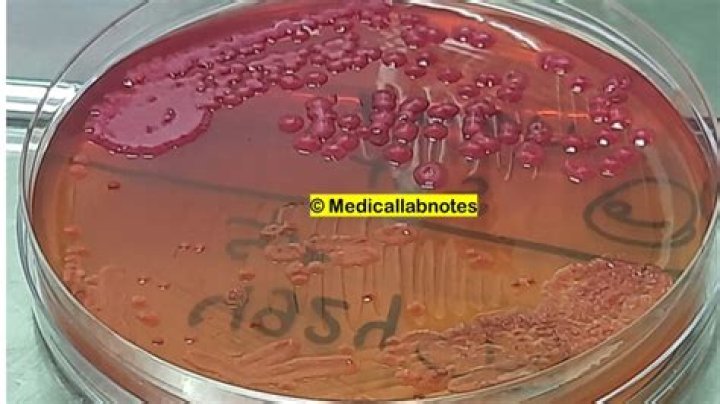

Where does stenotrophomonas come from?
Stenotrophomonas maltophilia (S. maltophilia) is a free living, motile, aerobic, oxidase negative, glucose non-fermentative Gram-negative bacillus (GNB). It is frequently isolated from water, soil, animals, plants, and hospital equipment (1–5).
Where is Stenotrophomonas commonly found?
The most common sites of infection are the lungs and blood. When the lungs are infected, symptoms of S. maltophilia are similar to other bacterial pneumonia and may include fever, cough, mucus, shortness of breath, and chest pain.
How do you get Stenotrophomonas?
Sources of Stenotrophomonas maltophilia infections have included sink drains, hand-washing soap, contaminated disinfectants, nebulizers, and even hospital suction tubing.
Is Stenotrophomonas common?
Stenotrophomonas maltophilia previously known as (Xanthomonas) maltophilia is an aerobic gram-negative bacillus that is found in various aquatic environments. Although an uncommon pathogen in humans, S maltophilia infection in humans, especially nosocomial, has been increasingly recognized.
Can Stenotrophomonas be cured?
The treatment of choice for Stenotrophomonas maltophilia is trimethoprim-sulfamethoxazole (SXT). Fluoroquinolones (FQs) have in vitro activity against S.
Stenotrophomonas maltophilia
16 related questions foundWhat diseases are caused by Stenotrophomonas maltophilia?
maltophilia causes various infectious complications in immunocompromised individuals and these include bacteremia, endocarditis, respiratory tract infections, meningitis, urinary tract infections, skin and soft tissue infections, mastoiditis, bone and joint infections, peritonitis, typhlitis and biliary sepsis, wound ...
How can stenotrophomonas be prevented?
Effective infection control measures can minimize or limit the spread of this and other organisms in the ICU. Appropriate isolation procedures, rather than antimicrobial therapy, should be used to control the spread of S maltophilia.
What kills stenotrophomonas Maltophilia?
After the identification of the organism as S. maltophilia, antibiotic therapy was determined by isolate susceptibility; treatment included high-dose (>15 mg kg−1 of body weight day−1) trimethoprim-sulfamethoxazole (TMP-SMX), ofloxacin, or both. Six patients (31.5%) with S. maltophilia bacteremia died.
What does stenotrophomonas cause?
maltophilia causes various infectious complications in immunocompromised individuals and these include bacteremia, endocarditis, respiratory tract infections, meningitis, urinary tract infections, skin and soft tissue infections, mastoiditis, bone and joint infections, peritonitis, typhlitis and biliary sepsis, wound ...
Where does B cepacia come from?
cepacia outbreaks have been caused by contaminated medical products. This includes liquid docusate in 2016, contaminated mouthwash in 2005, and contaminated over-the-counter nasal spray in 2004. It can also be spread by person-to-person contact, contact with contaminated surfaces and exposure to B.
What is stenotrophomonas bacteremia?
Abstract. Objective Stenotrophomonas maltophilia is an emerging nosocomial pathogen that causes fatal infections in critically ill or immunocompromised patients. S. maltophilia bacteremia (SMB) is a rare condition, and its clinical characteristics in Japanese settings are not well known.
Does doxycycline cover stenotrophomonas?
Tetracyclines such as tigecycline, minocycline, and doxycycline are also effective agents and consistently display good activity against S.
How many cases of Stenotrophomonas are there?
Stenotrophomonas maltophilia represents the fourth most common pathogen among nonfermenting gram-negative bacteria (following Pseudomonas aeruginosa, Acinetobacter spp, and Burkholderia cepacia complex), with a reported incidence of 7.1 to 37.7 cases/10 000 discharges (regarding nosocomial infections)20.
Why is Stenotrophomonas resistant to antibiotics?
Introduction: Stenotrophomonas maltophilia is a prototype of bacteria intrinsically resistant to antibiotics. The reduced susceptibility of this microorganism to antimicrobials mainly relies on the presence in its chromosome of genes encoding efflux pumps and antibiotic inactivating enzymes.
Where is Klebsiella oxytoca found?
Klebsiella oxytoca (KO) is one of several Klebsiella bacteria. These bacteria are naturally found in the intestinal tract, mouth, and nose. They're considered healthy gut bacteria inside your intestines. Outside the gut, however, these bacteria can cause serious infections.
Is stenotrophomonas Maltophilia serious?
Purpose: Stenotrophomonas maltophilia has low pathogenicity potential, but if it causes bacteremia it can be fatal, because it has shown high resistance to many antibiotics and can be difficult to treat. Patient death from S. maltophilia bacteremia has increased since 2014 in our hospital.
What antibiotics is stenotrophomonas Maltophilia resistant to?
Levofloxacin was found to be the most effective antibiotic against S. maltophilia strains with resistance rate of 7.6%. The resistance rates to other antibiotics were as follows: chloramphenicol 18.2%, trimethoprim-sulfamethoxazole 20.3% and ceftazidime 72%.
How does someone get bacteremia?
Some common ways in which bacteremia occurs include: through a dental procedure such as a routine teeth cleaning or through a tooth extraction. from a surgery or procedure. an infection spreading from another part of the body into the bloodstream.
Does stenotrophomonas need isolation?
maltophilia being a highly virulent pathogen in this setting. Given the high frequency of multiple pathogens, in the absence of consolidation, isolation of S. maltophilia may not require antibiotic therapy as the majority of patients in this group do not appear to benefit from treatment.
Is bacteremia an infection?
Bacteremia is an infection, caused by bacteria, that enters the bloodstream. It may also be referred to as septicemia, sepsis, septic shock, blood poisoning, or bacteria in the blood.
Is Burkholderia pathogenic?
Burkholderia is a genus of Proteobacteria whose pathogenic members include the Burkholderia cepacia complex, which attacks humans and Burkholderia mallei, responsible for glanders, a disease that occurs mostly in horses and related animals; Burkholderia pseudomallei, causative agent of melioidosis; and Burkholderia ...
What kind of bacteria is stenotrophomonas Maltophilia?
Stenotrophomonas (Xanthomonas) maltophilia is a multidrug-resistant gram-negative bacillus that is an opportunistic pathogen [1-4], particularly among hospitalized patients. S. maltophilia infections have been associated with high morbidity and mortality in severely immunocompromised and debilitated individuals.
Is stenotrophomonas resistant to antibiotics?
Introduction: Stenotrophomonas maltophilia is a prototype of bacteria intrinsically resistant to antibiotics. The reduced susceptibility of this microorganism to antimicrobials mainly relies on the presence in its chromosome of genes encoding efflux pumps and antibiotic inactivating enzymes.
What is the shape of stenotrophomonas?
Curved, straight or bean-shaped: bacilli come in many variants and are widely spread. Stenotrophomonas maltophilia is an aerobic, Gram-negative, rod-shaped bacterium of the Xanthomonadaceae family. It may trigger urinary tract infection, respiratory tract infection or bloodstream infection.



